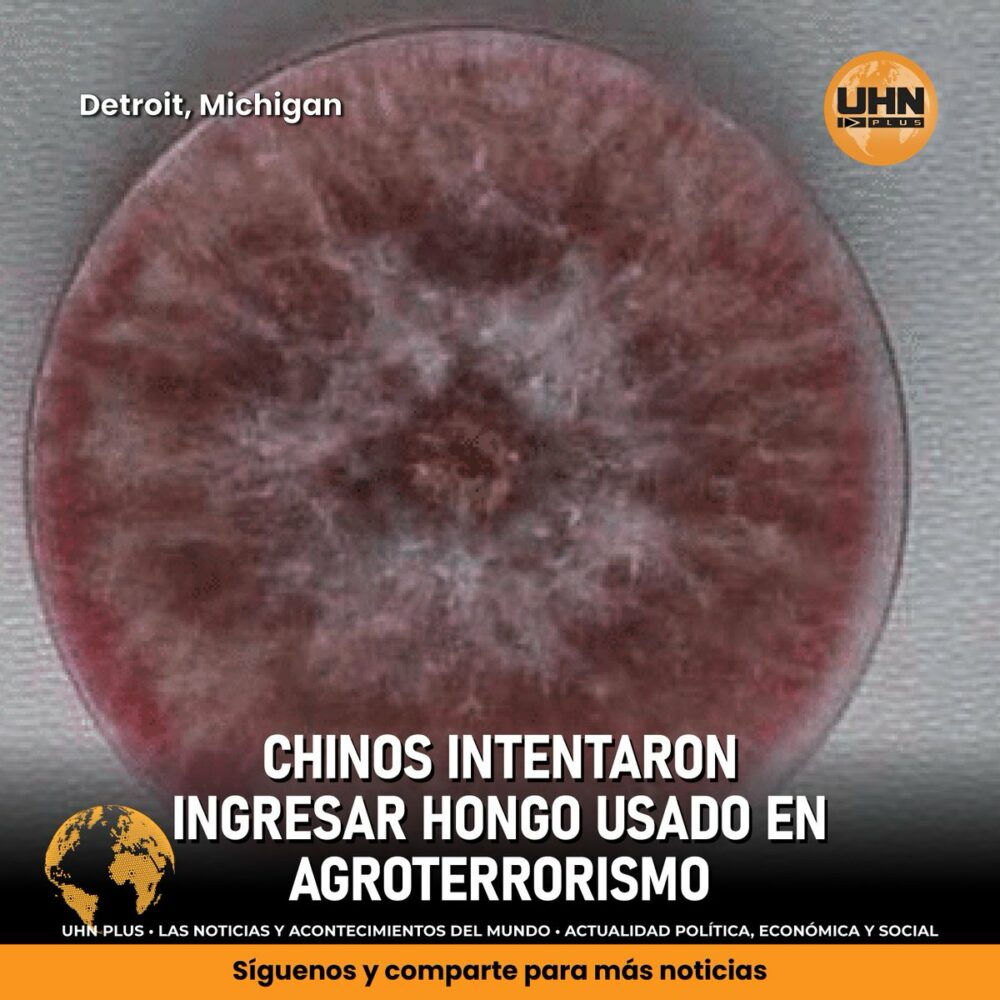

🇺🇸🇨🇳 | ATENCIÓN — Una investigadora china y su pareja fueron acusados en EE.UU. por intentar introducir un hongo devastador que destruye cultivos y puede usarse como arma biológica. El patógeno fue hallado en el equipaje del hombre al llegar a Detroit.
El hongo, prohibido en https://t.co/LDnPc9OzaX
Fuente: UHN Plus